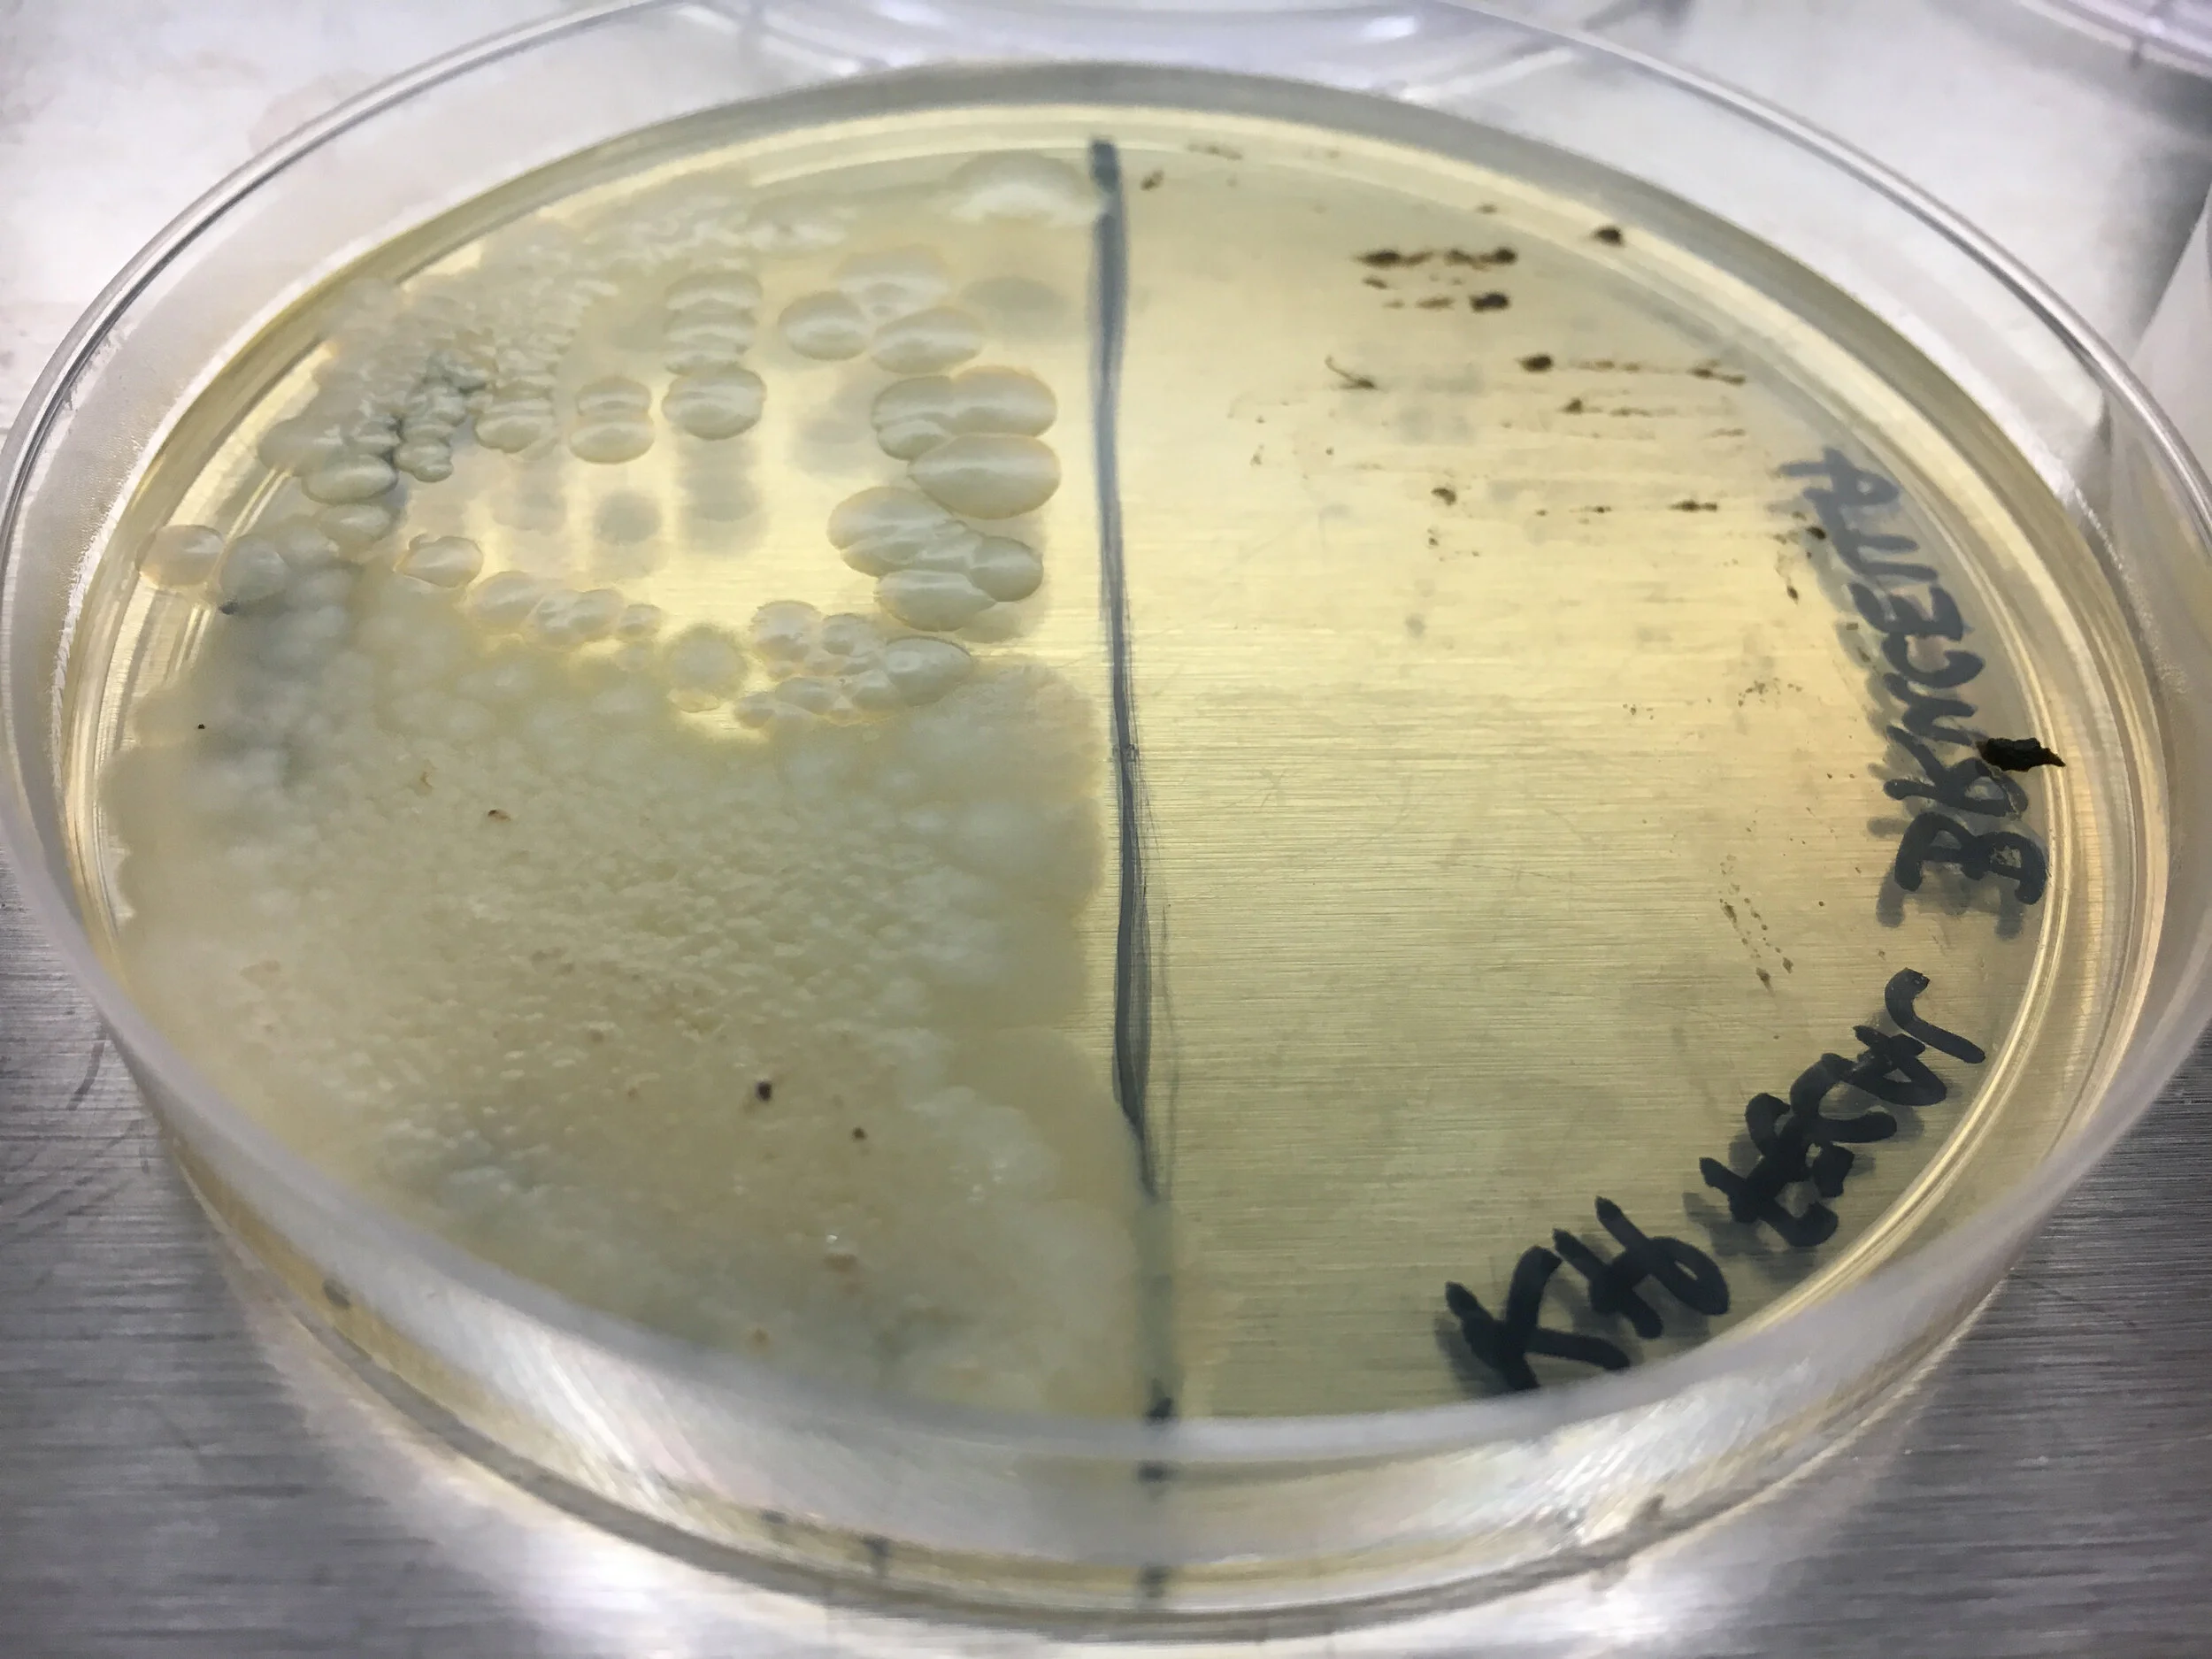

Landscape of Lost Microbes (2017)
Landscape of Lost Microbes, 2017. Installation view. Esther Klein Gallery. Photo: Jamie Alvarez
Conceived by:
Kathy High and William DePaolo, DePaolo Lab, UW
Photographer:
Kathy High
Landscape of Lost Microbes (2017) — Kathy High and William DePaolo, DePaolo Lab, University of Washington
Research series on missing microbes.
Kathy High and Dr. William DePaolo plated their own fecal samples side by side on agar petri dishes. In plate after plate, DePaolo’s bacteria was productive and diverse. But High’s side of the petri dish repeatedly came up empty, evidence of a condition of “dysbiosis” – or missing microbes.
Is this our 21st century human condition?